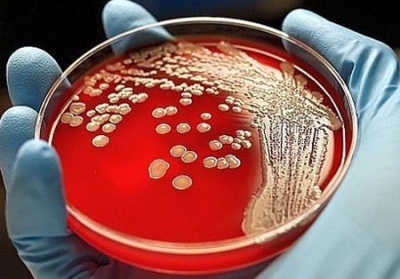

A levegő a vizeletben, a vizelet a légbuborékokat
Vannak olyan esetek, amikor a beteg vizelés közben, érzékeli a levegő a vizeletben. Bár bizonyos esztétikai hatása a megfigyelése ezt a jelenséget meg kell venni, hogy felelősen butilátot vizelettel, nevezetesen úgy néz ki, a gáz, mint például a légbuborékok a vizeletben, bár nagyon ritka, de azt sugallja, hogy a lehetséges súlyos betegség a húgyúti rendszer.
Mi pnevmaturiya?

- Levegő a húgyhólyag alatt katéterezés.
- Légbuborékok a vizeletben lehet eredménye a beteg előkészítése cisztoszkópia (húgyhólyag vizuális vizsgálat egy speciális optikai szálas eszköz) vagy cystogram (Röntgen hólyag). Ehhez meg kell adni az üregbe, a húgyhólyag vagy az oxigén vagy szén-dioxid.
- Ezeket a gázokat használt készítményben egy másik X-ray tanulmány - pnevmopielogarfii.
- A jelenléte a külső húgycső sipoly, ami ahhoz vezethet, hogy a spontán levegőt a vizeletben.
- Urológusok mondjuk a lehetőségét, egyre gáz a bélből jelenlétében patológiai gyomor-vizelet vagy vesico-vaginális sipoly.
- A cukorbetegség képződése jellemzi a gázok a hólyagban, mivel magas koncentrációban a glükóz - colibacteria és számos más szerek egy patológiás állapot okozza bomlása a glükóz.
Egyéb okok pnevmaturii
Amint kellemetlen fenti okok miatt, hogy hatással lehet a levegő a vizeletben, de a sipoly közötti a bél és a hólyag okozhatja a kapott trauma és több veszélyes betegség - a malignus vastagbélrák, prosztatarák.
Mindenesetre - megfigyelni a megjelenése légbuborékok a vizeletben, meg kell tenni egy orvos hírnevét. Ebben az esetben ez lesz rendelve egy sor laboratóriumi vizsgálatok egyaránt magában mikroszkópos vizsgálata a vizelet, amelynek célja az azonosítási mikroorganizmusok okozhat vizelet fermentációs folyamat, valamint a vérvizsgálatok.
Hiányában látható megnyilvánulásai olyan betegség, ami azt eredményezheti, hogy a megjelenése légbuborékok a vizeletben, arra van szükség, hogy végezzen alapos vizsgálatot, amelynek célja megszüntetése lehetőségének látens rák. A szükséges felmérés komplex nevezi orvos.
Ajánlott Kapcsolatban
A veszélyes baktériumok Klebsiella?

Mennyire veszélyes egy kő ragadt a húgyvezeték?

Urológus vagy Nephrológus - egy orvos a vesében?
